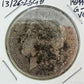
1899-O US 90% Morgan Silver Dollar G-VG #13126-23GH

Mountain of Jewels
1899-O US 90% Morgan Silver Dollar G-VG #13126-23GH
1899-O US 90% Morgan Silver Dollar G-VG #13126-23GH
Couldn't load pickup availability
1899-O US 90% Morgan Silver Dollar G-VG #13126-23GH.
Own a piece of an American History that will stay with you forever.
A perfect gift for your son or daughter or grandkids. Have them start a collection from young age.
- Category: Morgan Dollars (1878-1921)
- Mint: New Orleans
- Mintage: 12,290,000
- Obverse Designer: George T. Morgan
- Reverse Designer: George T. Morgan
- Composition: Silver
- Fineness: 0.9
- Weight: 26.73g
- ASW: 0.7734oz
- Diameter: 38.1mm
- Edge: Reeded
The coin you see in the pictures is the coin you'll get. Please note that we are selling our coins AS IS. We never clean, polish, or plate out coins! The coin may have some scratches, pits, and blemishes, so please be aware of that. We grade the coin to be GOOD TO VERY GOOD, but please view all pictures for details and condition and make your own assessment.
Listed with ExportYourStore.com
Shipping & Returns
Shipping & Returns
Shipping
Domestic:
Mountain of Jewels offer free insured USPS shipping on all domestic purchases. In most cases your order will be shipped the same day however if ring sizing needed or some modification to a piece of jewelry this could take up to 7 business days.
Item that is less than $50 will be charged $6 shipping.
Every item over $200 will be shipped with Signature Guaranteed.
FedEx 2nd Day is $45 and $5 for any additional item.
FedEx Standard Overnight is $60 and $5 for any additional item.
You will receive an email notification and a tracking number to easily track your shipment online once your order is shipped. Shipping time is location dependent and usually takes 2-4 business days. Your order will be shipped to your registered and verified PayPal address ONLY.
International:
We normally select the most inexpensive shipping and insurance method possible for our international buyers. We mostly use USPS Priority Mail Express International for $20 for items up to $1000 in value. All other shipments that are over $1000 will be sent via FedEx. Shipping cost will be quoted to you based on the destination and purchase value. Your country of residence may impose customs, import, duties, or tax fees that you must pay because your order originated outside your home country. These fees are your responsibility and are separate from the cost you paid us for you merchandise and shipping.
Our goal is to ship your order as quickly as possible, however, there are matters that are out of our control such as custom delays and freight carrier's shipping service. If you are interested to find out the expected date of shipment of a particular product, use the tracking number you were provided with, following your purchase. We are not responsible for any customs charges or holdups.
Please note that we CANNOT mark the customs tag as a "gift" or to value the order at less than what you paid for the merchandise. This practice is considered fraud and violations of this policy carry severe penalties and can result in our loss of international shipping privileges. For additional information, please contact the customs department in your country.